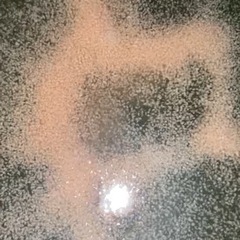
サムネイル

キスオンザグリーン ゴルフポロシャツ(投稿ID : 1c8fy2)
更新2025年8月15日 11:01
作成2024年8月31日 23:19
使用回数は1回 写真ではシワがありますが 状態はとても綺麗で未使用に近いです お家クリーニング済なのでシワがあり 申し訳ありません アイロンで綺麗になります 上品なカラーバリエが人気の秘密!やわらかくストレッチの効いた生地で動きやすさもバツグン♪ウエストのくびれがキレイに出るように計算されたシンプルな定番ポロシャツ! ■カラー:ブラック サイズ2 ■素材:綿95%、ポリウレタン5% ■商品特徴: ・ストレッチカノコ素材使用 ・左胸ロゴ刺繍入り
その他の売ります・あげますの関連記事
キスオンザグリーン ゴルフポロシャツ 愛知 中古あげます・譲りますを見ている人は、こちらの記事も見ています。